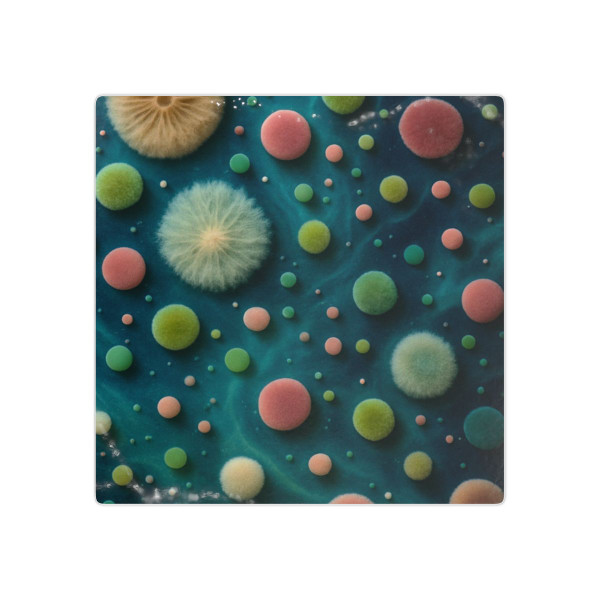
Microbial Galaxy - Temporary Tattoos

Product Overview
Explore your style with our Microbial Galaxy Temporary Tattoos! Each unique design bursts with vivid colors and cosmic creativity, allowing you to express your individuality effortlessly. These skin-safe tattoos are perfect for all ages, offering a playful, temporary way to showcase your personality at any event. Easy to apply and remove, they are a fun fashion accessory that invites compliments and sparks conversations. Transform your look in seconds and let the galaxy be your canvas!
Product features
- Lasting and vibrant designs that mimic realistic tattoos.
- Globally certified for safety under both toys and cosmetics regulations.
- Sourced from the United Kingdom for quality craftsmanship.
- Quick and easy application and removal process.
- Available in five sizes to suit everyone's style and preference.
Care instructions
- Apply to clean, dry skin. Place the tattoo face down on the skin. Wet a sponge or cloth and use it to soak the entire back of the tattoo. Wait 20-30 seconds, then slowly slide the paper away and lift off the skin. To remove the tattoo, apply a small amount of baby oil, then rub off using a warm, damp cloth. Not recommended for children under 3 years old.
| S (2" x 3") | M (3" x 4") | L (4" x 6") | XL (7.75" x 7.75") | XXL (11.75" x 11.75") | |
|---|---|---|---|---|---|
| Width, in | 2.00 | 3.00 | 4.00 | 7.75 | 11.75 |
| Height, in | 3.00 | 4.00 | 6.00 | 7.75 | 11.75 |